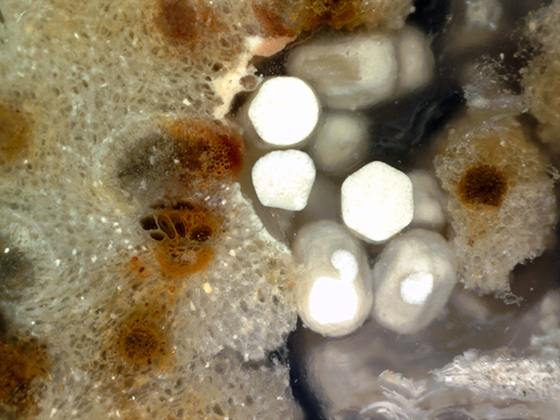
Termite Coprolites in Fossil Palm
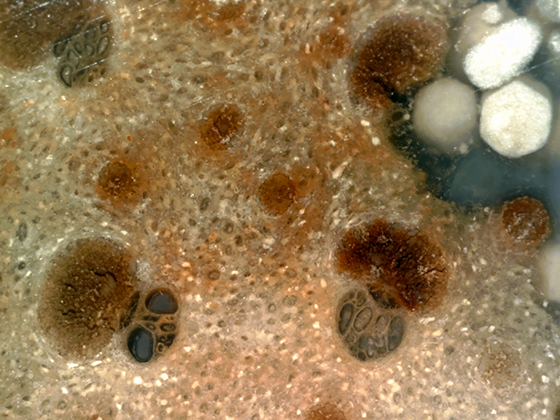
Oligocene Termite Coprolites
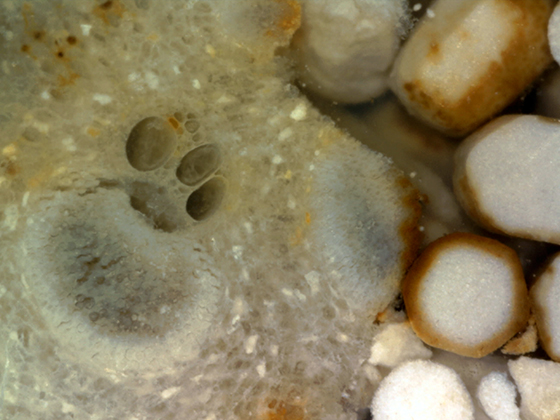
Termite Coprolites

|
 |
Cenozoic
Era: 65.5 Million Years to Present
Oligocene Epoch: 33.9-23 Million Years Ago
Gallery: Louisiana
Oligocene Epoch: 33.9-23 Million Years Ago
Gallery: Louisiana
 Palmoxylon Cenozoic; Paleogene; Oligocene Catahoula Formation Louisiana, USA 15 cm x 16 cm x 12 cm tall The Shreveport Collection |
This is one of only two specimens from the collection that includes trace fossils. Pockets of termite coprolites can be seen in this cross-section with close-ups below. This specimen also exhibits a multitude of colors. |
 |
The first two images were taken with a Canon PowerShot SD770 IS Digital ELPH 10.0 MEGA PIXELS. The images were taken in sunlight outside. The third image zooms in at 150x with a Dino-Lite AD7013 MT 5.0 MP. Images were resized in Adobe Photoshop CS6. Individual coprolites are 1 mm in length. |
 |
 |
|
The first image was taken with a Canon PowerShot SD770 IS Digital ELPH 10.0 MEGA PIXELS. The second image zooms in at 80x and was taken with a Dino-Lite AD7013 MT 5.0 MP. Images were resized in Adobe Photoshop CS6. |
 |
|
The next two images were taken at with a Dino-Lite AD7013 MT 5.0 MP. Images were resized in Adobe Photoshop CS6. The first image is at 80x and the second at 150x. |
|
 |